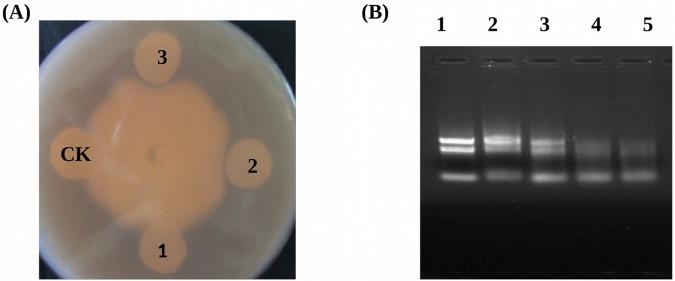

一种新型病程相关蛋白基因(GmPRP)的分离与鉴定,该基因在大豆疫霉感染大豆(Glycine max)过程中诱导表达
Isolation and Characterization of a Novel Pathogenesis-Related Protein Gene (GmPRP) with Induced Expression in Soybean (Glycine max) during Infection with Phytophthora sojae.
作者信息
Jiang Liangyu, Wu Junjiang, Fan Sujie, Li Wenbin, Dong Lidong, Cheng Qun, Xu Pengfei, Zhang Shuzhen
机构信息
Soybean Research Institute, Key Laboratory of Soybean Biology of Chinese Education Ministry, Northeast Agricultural University, Harbin, 150030, Heilongjiang, People's Republic of China.
Soybean Research Institute, Heilongjiang Academy of Agricultural Sciences, Collaborative Innovation Center of Grain Production Capacity Improvement in Heilongjiang Province, Harbin, 150086, Heilongjiang, People's Republic of China.
出版信息
PLoS One. 2015 Jun 26;10(6):e0129932. doi: 10.1371/journal.pone.0129932. eCollection 2015.
Pathogenesis-related proteins (PR proteins) play crucial roles in the plant defense system. A novel PRP gene was isolated from highly resistant soybean infected with Phytophthora sojae (P. sojae) and was named GmPRP (GenBank accession number: KM506762). The amino acid sequences of GmPRP showed identities of 74%, 73%, 72% and 69% with PRP proteins from Vitis vinifera, Populus trichocarpa, Citrus sinensis and Theobroma cacao, respectively. Quantitative real-time reverse transcription PCR (qRT-PCR) data showed that the expression of GmPRP was highest in roots, followed by the stems and leaves. GmPRP expression was upregulated in soybean leaves infected with P. sojae. Similarly, GmPRP expression also responded to defense/stress signaling molecules, including salicylic acid (SA), ethylene (ET), abscisic acid (ABA) and jasmonic acid (JA). GmPRP was localized in the cell plasma membrane and cytoplasm. Recombinant GmPRP protein exhibited ribonuclease activity and significant inhibition of hyphal growth of P. sojae 1 in vitro. Overexpression of the GmPRP gene in T2 transgenic tobacco and T2 soybean plants resulted in enhanced resistance to Phytophthora nicotianae (P. nicotianae) and P. sojae race 1, respectively. These results indicated that the GmPRP protein played an important role in the defense of soybean against P. sojae infection.
病程相关蛋白(PR蛋白)在植物防御系统中发挥着关键作用。从感染大豆疫霉(P. sojae)的高抗大豆中分离出一个新的病程相关蛋白基因,并将其命名为GmPRP(GenBank登录号:KM506762)。GmPRP的氨基酸序列与葡萄(Vitis vinifera)、毛果杨(Populus trichocarpa)、甜橙(Citrus sinensis)和可可树(Theobroma cacao)的病程相关蛋白分别具有74%、73%、72%和69%的同一性。实时定量逆转录PCR(qRT-PCR)数据表明,GmPRP在根中的表达最高,其次是茎和叶。在感染大豆疫霉的大豆叶片中,GmPRP的表达上调。同样,GmPRP的表达也对包括水杨酸(SA)、乙烯(ET)、脱落酸(ABA)和茉莉酸(JA)在内的防御/胁迫信号分子作出反应。GmPRP定位于细胞质膜和细胞质中。重组GmPRP蛋白在体外表现出核糖核酸酶活性,并对大豆疫霉1的菌丝生长有显著抑制作用。在T2转基因烟草和T2大豆植株中过表达GmPRP基因,分别增强了对烟草疫霉(P. nicotianae)和大豆疫霉1号生理小种的抗性。这些结果表明,GmPRP蛋白在大豆抵御大豆疫霉感染的防御中发挥着重要作用。